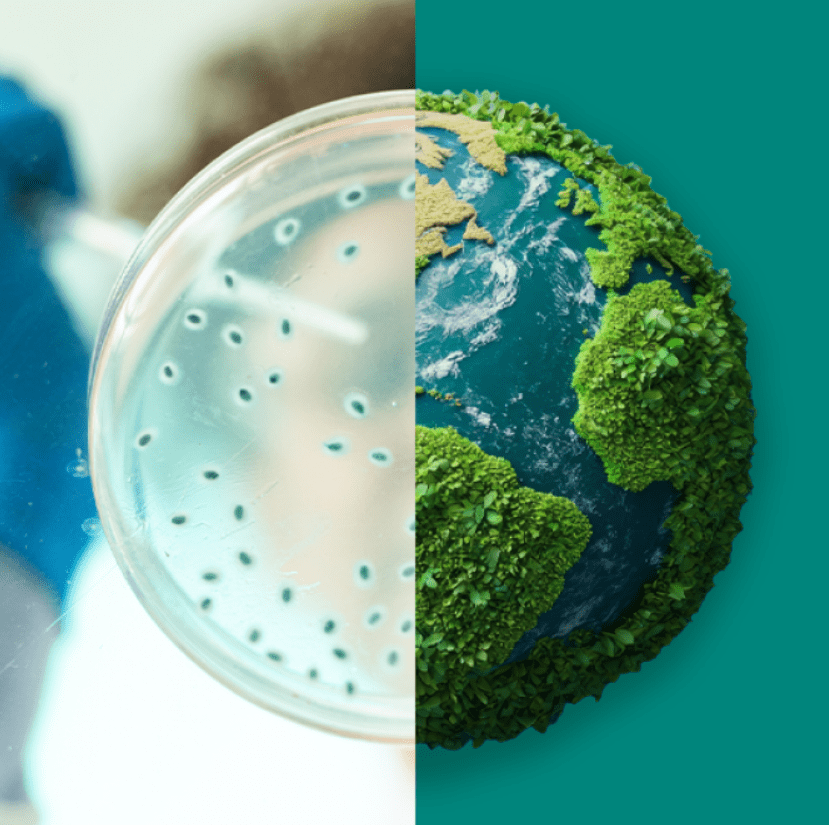

Sostenibilità
Operiamo responsabilmente ogni giorno per migliorare la salute umana e animale, oggi e in futuro.
Scarica il nostro Impact Report 2024/2025
Scarica il Summary del nostro Impact Report 2024/2025
La sostenibilità è al centro del nostro modo di operare
Dal garantire l’accesso alle cure al perseguimento di obiettivi di sostenibilità ambientale, il nostro Purpose for Progress: MSD Impact Report 2024/2025 mostra come la nostra azienda stia generando un impatto concreto — per le Persone, le comunità e il pianeta. Il nome sottolinea come il nostro scopo sia una bussola che guida ogni nostra azione. Perché il progresso non accade per caso. Si costruisce — grazie alle Persone, con uno scopo chiaro.
Guarda: l’impatto della nostra azienda

Il nostro impatto in numeri
Persone raggiunte con i nostri farmaci e vaccini nel 2024.
Persone iscritte ad almeno uno dei nostri 10 gruppi aziendali di “Employee Business Resource” — quasi il 30% della nostra forza lavoro globale. Tutti i dipendenti possono aderire liberamente a qualsiasi gruppo.
Anno in cui ci poniamo di raggiungere l’obiettivo di emissioni net-zero di gas serra in tutte le nostre operazioni globali (Scope 1, 2 e 3), in linea con le direttive della Science-Based Targets initiative (SBTi).
Disponibilità costante del nostro strumento di segnalazione etica, che consente a dipendenti e terze parti di fare segnalazioni in modo confidenziale e anonimo (dove consentito dalla legge).

Accesso alla Salute
Le innovazioni nel mondo della Salute hanno il massimo impatto quando raggiungono le Persone che ne hanno bisogno. Nel 2024, i nostri prodotti sono arrivati nel 92% dei Paesi del mondo.
Accesso alla Salute in sintesi:
Fact sheet: il nostro impatto in numeri
Infografica: espandere l’Accesso alla Salute

Persone
Le nostre Persone sono al centro del nostro purpose. Nel 2024, i nostri dipendenti hanno dedicato oltre 3 milioni di ore alla formazione, spaziando dall’apprendimento pratico allo sviluppo della leadership. Investiamo nella crescita, nel benessere e nelle opportunità affinché ogni persona possa guidare con consapevolezza e contribuire a costruire il futuro.
Persone in sintesi:
Fact sheet: le nostre Persone in numeri
Infografica: valorizzare le Persone attraverso apprendimento e crescita

Sostenibilità ambientale
Stiamo lavorando per un futuro in cui Persone e pianeta possano prosperare. Ci siamo impegnati a utilizzare il 100% dell’elettricità acquistata da fonti rinnovabili entro il 2025. Tutto questo fa parte del nostro percorso verso l’obiettivo di emissioni net-zero.
Sostenibilità ambientale in sintesi:
Fact sheet: il nostro impatto per la sostenibilità ambientale in numeri
Infografica: promuovere la Salute parte da un pianeta sano

Etica e valori
Siamo guidati dai valori e animati dall’integrità. Nel 2024, oltre il 99% dei nostri dipendenti ha completato la formazione sull’etica e abbiamo investito 4 miliardi di dollari presso piccoli fornitori Tier 1 e 2 a livello globale, promuovendo una filiera sana. È così che ogni giorno, ovunque operiamo, costruiamo fiducia.
Etica e valori in sintesi:
Fact sheet: il nostro impegno riguardo Etica e valori in numeri
Infografica: Speak up – Promuoviamo una cultura dell’integrità
Corriamo verso le più grandi sfide sanitarie globali
Dalla ricerca di soluzioni per alcune delle malattie più debilitanti presenti al mondo, al mettere a disposizione farmaci e vaccini a chi ne ha bisogno, alla costruzione di sistemi sanitari più efficaci, siamo sempre in missione per creare un mondo migliore.
Il nostro approccio
Operare responsabilmente è alla base della nostra capacità di avere un impatto sostenibile e di portare valore di lungo termine alla nostra azienda e alla società di cui facciamo parte.
Indirizziamo le risorse e le attività verso 4 aree di interesse:
Accesso alla Salute
In collaborazione con i nostri stakeholder, lavoriamo per assicurare che la nostra scienza impatti positivamente sul Sistema Salute e che i nostri prodotti siano accessibili a chi ne ha più bisogno.

Utilizzare la Ricerca e la Scienza per salvare e migliorare la vita delle Persone
Investiamo in Ricerca&Sviluppo e puntiamo su patologie dove possiamo fare la differenza.

Ricerca sulle malattie infettive e sviluppo di vaccini
Ci impegniamo nel sostenere l’impatto delle malattie infettive sulla Salute pubblica globale.

Lavorare con partner che condividono il nostro stesso impegno
Attraverso partnership, investimenti e invenzioni, cerchiamo di superare barriere che impediscono un futuro più sano per tutti.
Persone
Siamo consapevoli che la nostra capacità di eccellere dipende dall’integrità, dal know-how, dalla competenza, dalla diversità e dal benessere delle nostre Persone.

Learning & development
Investiamo in formazione e sviluppo perchè la nostra cultura ruota attorno alla curiosità.

Un approccio olistico per prestare attenzione al benessere delle nostre Persone
Solo quando i nostri dipendenti si sentono al meglio, in tutti gli aspetti della loro vita, possono dare il massimo.


Donazioni
Il modo migliore per raccontarci è attraverso quello che facciamo per gli altri.

MSD CrowdCaring
MSD Italia cofinanzia i progetti innovativi per la Vita delle Persone. MSD CrowdCaring nasce per supportare progetti innovativi che possano migliorare la Salute e la Qualità di Vita delle Persone favorendo l’Inclusione, l’Equità e la Diversità.
Sostenibilità Ambientale
Consideriamo l’impatto delle nostre attività e ci sforziamo di operare in modo sostenibile per salvaguardare la Salute del nostro pianeta e dei suoi abitanti.

Operare in maniera efficiente
Conservazione dell'energia, riduzione dell'uso dell'acqua, uso efficiente delle materie prime e gestione responsabile dei rifiuti.

Design per l'ambiente
Adottiamo strategie di sostenibilità per ridurre l'impatto ambientale.

Riduzione degli impatti della supply chain
Collaboriamo con i nostri fornitori e clienti per comprendere e ridurre al minimo gli impatti del ciclo di vita dei nostri prodotti.
Etica & Valori
Grazie al nostro grande impegno in termini di trasparenza, otteniamo la fiducia dei nostri interlocutori.

I nostri valori e standard
Il nostro codice di condotta è alla base del nostro agire e ci aiuta a consolidare la nostra reputazione di azienda affidabile.

Diritti umani
Ci impegniamo ad individuare e prevenire le violazioni dei diritti umani e del lavoro nelle nostre attività e lungo la nostra supply chain.

Etica nella vendita e nel marketing
In tutte le nostre attività seguiamo rigorose pratiche etiche di vendita e marketing.



